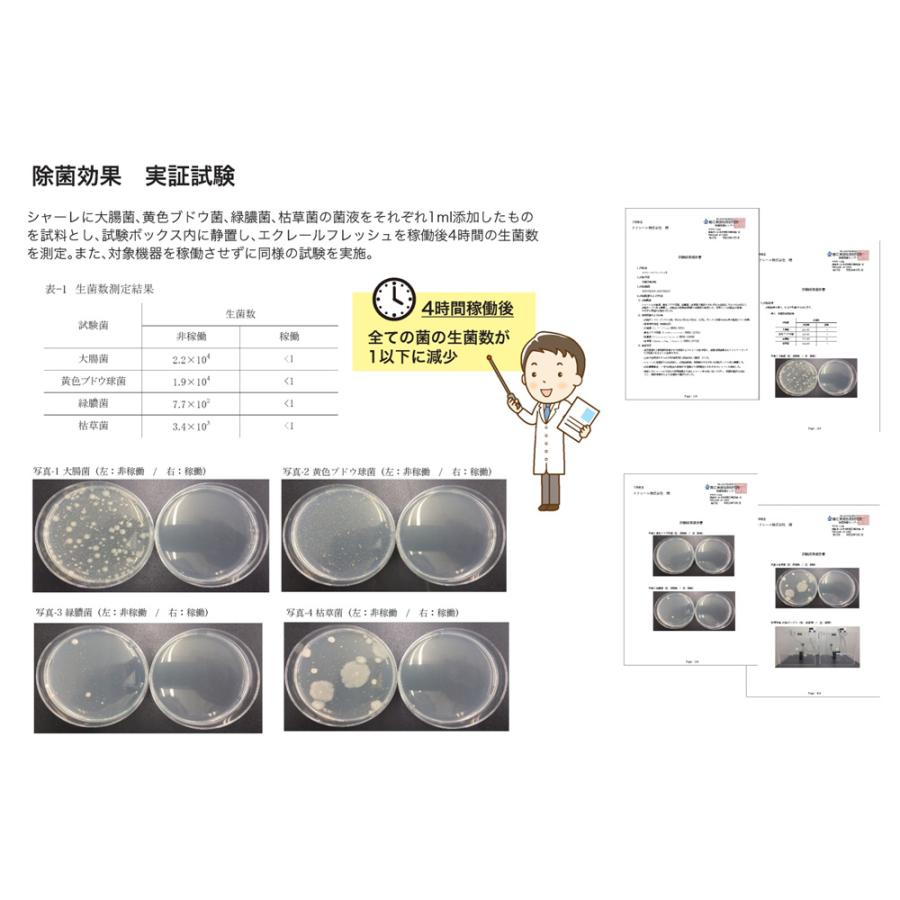
低濃度オゾン発生器 オゾンプロテクト 低濃度オゾン発生装置 新型

オゾンプロテクト 低濃度オゾン発生器 低濃度オゾン発生器 オゾンプロテクト 低濃度オゾン発生装置 新型
(3311件)
Pontaパス特典
サンキュー配送
12760円(税込)
128ポイント(1%)
Pontaパス会員ならさらに+1%ポイント還元!
送料
(
)
3302
配送情報
お届け予定日:2026.04.24 14:2までにお届け
※一部地域・離島につきましては、表示のお届け予定日期間内にお届けできない場合があります。
ロットナンバー
4361853325
お買い物の前にチェック!

Pontaパス会員なら
ポイント+1%
ポイント+1%
商品説明





ウイルスや花粉PM2.5を効果的に除去する低濃度オゾン発生器広い部屋には2つ必要かと思って2台買いましたが1台で充分だったので、未使用を出品します✴︎本体✴︎プレート2枚✴︎説明書替えのチップあります#haaaruオゾンプロテクト- 製品名: オゾンプロテクト- 機能: 低濃度オゾン発生器- メンテナンス方法: プレート交換式- 用途: ウイルス・花粉・PM2.5対策- 電源: コンセント式
| カテゴリー: | 生活家電・空調>>>空気清浄機・イオン発生器>>>オゾン発生器 |
|---|---|
| 商品の状態: | 新品、未使用","新品で購入し、一度も使用していない |
| 配送料の負担: | 送料込み(出品者負担) |
| 配送の方法: | 佐川急便/日本郵便 |
| 発送元の地域: | 未定 |
| 発送までの日数: | 1~2日で発送 |
レビュー
商品の評価:




 4.5点(3311件)
4.5点(3311件)
- じぃたん。
- ただ、アルミが裂けてしまって、 結局、自宅用になってしまいました。 品質は良いのですけど・・
- アルディージャファン
- アフターシェイブに付けるために購入、有難うございました。
- tadaii
- 思ってたより香りは良くなかった。 保湿はふうつでした。
- ーのりのりー
- 送料が無料になるようにローションとセットで購入しました。 結構長く使ってますが、刺激が少なく、敏感肌の人にもおすすめ。 そこそこ量もあるので、コスパは、、まあまあかな。 しっとりはしますが、ベタつかないので、日焼け止めや下地に混ぜて メイクの前に塗ったりもします。 すぐかゆくなってしまうので、低刺激のこちらの商品は欠かせないです。
- Siva10
- 製造終了ということなので購入しておきました。匂いにも癒されます!
- 爆笑なら
- 友人が使ってよかったといったので、プレゼント用にしました。
すべて見る
お店の情報
7,367
連絡・応対
4.3
配送スピード
4.3
梱包
4.3